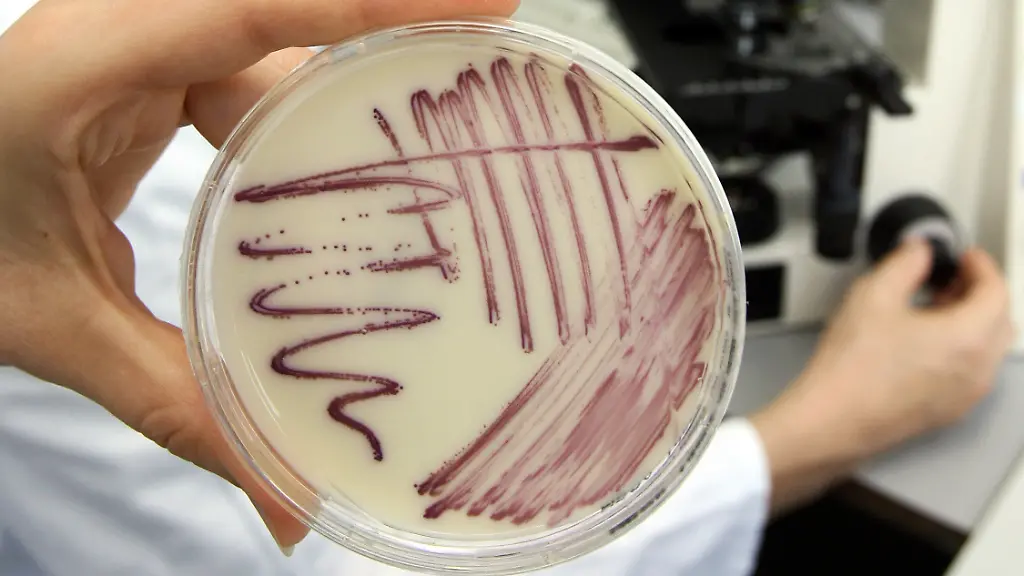
1a8c708cc4428b4f3fab2d42546083b0

Für Kampf gegen tödliche Keime?Neues Antibiotikum in der Nase entdeckt
Seit Langem wird nach einem Weg gesucht, Bakterien zu bekämpfen, gegen die gängige Antibiotika nicht helfen, denn jedes Jahr sterben in deutschen Krankenhäusern tausende Menschen an Infektionen durch die multiresistenten Keime. In der Nase werden Forscher fündig.
Ausgerechnet in der menschlichen Nase haben deutsche Forscher ein neues Antibiotikum entdeckt. Der Stoff mit dem Namen Lugdunin tötet Laborbefunden zufolge auch Bakterienstämme, die gegen andere Antibiotika resistent sind. Produziert wird der Stoff vom Bakterium Staphylococcus lugdunensis, das bei einem kleinen Teil der Menschen natürlicherweise in der Nase vorkommt.
Andreas Peschel von der Universität Tübingen und seine Kollegen berichten über ihre Entdeckung im Fachmagazin "Nature". Noch ist es allerdings ein weiter Weg bis zu einer etwaigen Zulassung als Medikament, so verweisen andere Forscher auf mögliche Nebenwirkungen.
"Diese Erreger in Krankenhäusern ein großes Problem"
Bakteriologen suchen seit vielen Jahren nach einem Weg, Methicillin-resistente Staphylococcus aureus (kurz MRSA) zu bekämpfen. "Diese Erreger sind in Krankenhäusern ein großes Problem, jedes Jahr sterben mehrere 1000 Menschen in Deutschland durch MRSA-Infektionen", berichtet Peschel. Es gebe sogar Schätzungen, nach denen in den kommenden Jahrzehnten mehr Menschen an antibiotikaresistenten Bakterien sterben könnten als an Krebs, hebt Co-Autor Bernhard Krismer laut einer Pressemitteilung der Universität Tübingen hervor.
Die Forscher sahen sich die mikrobiologische Lebensgemeinschaft in der menschlichen Nase an, wo das Bakterium Staphylococcus aureus bei etwa einem Drittel der Bevölkerung natürlicherweise vorkommt. Bei gesunden Menschen ist das kein Problem, doch bei Kranken und Geschwächten wird Staphylococcus aureus zu einer tödlichen Gefahr.
Zahlreiche Bakterienstämme wurden im Labor einzeln mit Staphylococcus aureus zusammengebracht, darunter auch verschiedene Arten der Gattung Staphylococcus. Bei Staphylococcus lugdunensis zeigte sich ein Rückgang von Staphylococcus aureus, bis hin zum kompletten Absterben. Die Wissenschaftler entdeckten einen neuen Stoff, der den Tod von Staphylococcus aureus bewirkt und den sie Lugdunin nannten, sowie die Gene für seine Herstellung. Die weitere Forschung ergab, dass Lugdunin auch bei anderen Bakterienstämmen hilft, die gegen Antibiotika resistent sind.
Geduldige Grundlagenforschung wichtig
"Die Entdeckung von Lugdunin zeigt wieder einmal, wie wichtig geduldige Grundlagenforschung ist", betont Peschel. Zusammen mit seinen Kollegen konnte er belegen, dass Lugdunin eine Staphylococcus-aureus-Infektion auf der Haut von Mäusen bekämpfen kann. Einen weiteren Hinweis auf die Wirksamkeit von Lugdunin brachten Proben aus den Nasen von 187 Menschen zu Tage: Bei Probanden, in deren Nase Staphylococcus lugdunensis siedelte, kamen nur in 5,9 Prozent der Fälle auch Staphylococcus aureus vor. Bei Patienten ohne Staphylococcus lugdunensis waren es 34,7 Prozent.
"Normalerweise werden Antibiotika nur von Bodenbakterien und Pilzen gebildet", wird Peschel in einer Pressemitteilung seiner Universität zitiert. "Die Vorstellung, dass die menschliche Mikroflora ebenfalls eine Quelle von antimikrobiellen Stoffen sein könnte, ist eine neue Entdeckung." Die Forscher hoffen, mit dieser Entdeckung eine Tür zu weiteren Quellen von Antibiotika geöffnet zu haben.
Chemisch gesehen bildet Lugdunin eine neue Stoffklasse, die sich zwar aus bekannten Aminosäuren zusammensetzt, deren Kombination aber keinem anderen bislang bekanntem Antibiotikum ähnelt. Besonders auffällig ist eine große Ringstruktur, in der Peschel auch den Ursprung für den Wirkmechanismus vermutet. In einem "Nature"-Kommentar bescheinigen Kim Lewis und Philip Strandwitz von der Northeastern University in Boston (USA), dass das Vorgehen der Tübinger Forscher einen allgemeinen Ansatz zur Suche nach Antibiotika bei Bakterien bietet, die den Menschen besiedeln.
Stoff könnte auch menschlichen Zellen gefährlich werden
Schwierigkeiten für eine klinische Anwendung von Lugdunin könnte jedoch der Wirkmechanismus bereiten, der wahrscheinlich an der Synthese größerer Zellstrukturen wie der Membran ansetze und somit möglicherweise auch menschlichen Zellen gefährlich werden könnte.
Dietmar Pieper vom Helmholtz-Zentrum für Infektionsforschung, der nicht an der Studie beteiligt war, geht davon aus, dass die Erforschung des neuen Wirkstoffs gerade erst begonnen hat: "Bei der Entwicklung von Antibiotika rechnet man in Jahrzehnten." Staphylococcus lugdunensis und Lugdunin müssten auf alle möglichen Wechselwirkungen im Körper hin genau untersucht werden. Insgesamt aber beurteilt er die Arbeit der Forscher als "gut gemachte Studie, die mir gefällt".